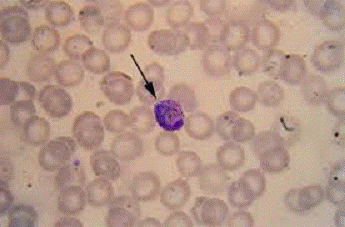

Паразиты, локализующиеся в сердечно-сосудистой системе
Государственное
бюджетное образовательное учреждение высшего профессионального образования
«Южно-Уральский государственный медицинский университет»
Министерства
здравоохранения Российской Федерации
Кафедра
медицинской биологии и генетики
плазмодий сердечный паразит миокардит
Научная
работа
Тема
научной работы: Паразиты, локализующиеся в сердечно-сосудистой системе
По
дисциплине: Биология
Челябинск
2015 год
Введение
В животном мире существует огромное количество
как одноклеточных, так и многоклеточных организмов. И форма взаимоотношения
всех этих организмов разнообразная: симбиоз, нахлебничество, паразитизм и т.д.
В природе широко встречается паразитизм как форма сожительства двух организмов,
выгодная для одного вида и вредная для другого. Так, например, для здоровья
человека некоторые виды представляют потенциальную опасность.
Наука, изучающая паразитов человека, вызываемые
ими болезни и методы борьбы с ними, называется медицинской паразитологией.
Паразиты могут поражать практически все органы и ткани человека. В своей работе
я хочу рассказать о паразитах, которые влияют на функциональную работу
сердечно-сосудистой системы.
Кровяные и сердечные паразиты
Малярийный плазмодий
Малярийные плазмодии относятся к классу
Plasmodium и являются возбудителями малярии. В организме человека паразитируют
следующие виды плазмодиев: P. vivax - возбудитель трехдневной малярии, P.
malariae - возбудитель четырехдневной малярии, P. falciparum - возбудитель
тропической малярии, P. ovale - возбудитель овалемалярии, близкой к трехдневной
(встречается только в Центральной Африке). Первые три вида обычны в тропических
и субтропических странах. Все виды плазмодиев имеют сходные черты строения и
жизненного цикла, отличие имеется лишь в отдельных деталях морфологии и
некоторых особенностях цикла.
Жизненный цикл типичен для споровиков и состоит
из бесполого размножения (шизогонии), полового процесса и спорогонии.
Малярия - типичное антропонозное трансмиссивное
заболевание. Переносчики - комары рода Anopheles (они же и окончательные
хозяева). Промежуточный хозяин - только человек.
Заражение человека происходит при укусе комара,
в слюне которого содержатся плазмодии на стадии спорозоита. Они проникают в
кровь, с током которой оказываются в ткани печени. Здесь происходит тканевая
(преэритроцитарная) шизогония. Она соответствует инкубационному периоду
болезни. В клетках печени из спорозоитов развиваются тканевые шизонты, которые
увеличиваются в размерах и начинают делиться шизогонией на тысячи дочерних
особей. Клетки печени при этом разрушаются, и в кровь попадают паразиты на
стадии мерозоита. Они внедряются в эритроциты, в которых протекает
эритроцитарная шизогония. Паразит поглощает гемоглобин клеток крови, растет и
размножается шизогонией. При этом каждый плазмодий дает от 8 до 24 мерозоитов.
Гемоглобин состоит из неорганической железосодержащей части (гема) и белка
(глобина). Пищей паразита служит глобин. Когда пораженный эритроцит лопается,
паразит выходит в кровяное русло, в плазму крови попадает гем. Свободный гем -
сильнейший яд. Именно его попадание в кровь вызывает страшные приступы
малярийной лихорадки. Температура тела больного поднимается так высоко, что в
старину заражение малярией использовали как средство лечения сифилиса
(испанской чесотки): трепонема не выдерживает таких температур. Развитие
плазмодиев в эритроцитах проходит четыре стадии: кольца (трофозоита),
амебовидного шизонта, фрагментации (образования морулы) и (для части паразитов)
образования гаметоцитов. При разрушении эритроцита мерозоиты попадают в плазму
крови, а оттуда - в новые эритроциты. Цикл эритроцитарной шизогонии повторяется
много раз. Рост трофозоита в эритроците занимает время, постоянное для каждого
вида плазмодиев. Приступ лихорадки приурочен к выходу паразитов в плазму крови
и пов торяется каждые 3 либо 4 дня, хотя при длительно текущем заболевании
чередование периодов может быть нечетким.
Из части мерозоитов в эритроцитах образуются
незрелые гамонты, которые являются инвазивной стадией для комара. При укусе
комаром больного человека гамонты попадают в желудок комара, где из них
образуются зрелые гаметы. После оплодотворения образуется подвижная зигота
(оокинета), которая проникает под эпителий желудка комара. Здесь она
увеличивается в размерах, покрывается плотной оболочкой, формируется ооциста.
Внутри нее происходит множественное деление, при котором образуется огромное
количество спорозоитов. Затем оболочка ооцисты лопается, плазмодии с током
крови проникают во все ткани комара. Больше всего их скапливается в его слюнных
железах. Поэтому при укусе комара спорозоиты могут проникнуть в организм
человека.
Таким образом, у человека плазмодий размножается
только бесполым путем - шизогонией. Человек - это промежуточный хозяин для
паразита. В организме комара протекает половой процесс - образование зиготы,
образуется множество спорозоитов (идет спорогония). Комар - это окончательный
хозяин, он же и переносчик (см. Приложение №1.). [9]
Трипаносома
Трипаносомы - род паразитических протистов из
отряда трипаносоматид; обитают в тропических и субтропических районах, причём
южноамериканский вид Trypanosoma cruzi является возбудителем болезни Шагаса, а
африканские виды данного рода - возбудителями сонной болезни[5].
Жгутиконосец Trypanosoma cruzi имеет длину 15-20
мкм. У позвоночных хозяев является внутриклеточным паразитом, в цикле развития
которого происходит смена нескольких жизненных форм. Так, проникая в клетки
различных органов и тканей, он превращается в амастиготу - форму, лишённую
жгутика и имеющую округлую или овальную форму. Размножение - внутриклеточное,
происходит с образованием промастигот (формы со жгутиком на переднем конце
клетки) размером около 2 мкм; последние позднее превращаются в S-образные
трипомастиготы (формы со жгутиком, отходящим на заднем конце клетки), которые
несут ундулирующую мембрану (образована участком жгутика, прилегающим к
поверхности жгутиконосца, и способствует извивающемуся движению последнего) и
поступают в русло крови.
На протяжении второй стадии паразиты
концентрируются, в основном, в сердце или мускулатуре пищеварительного тракта.
До 30% пациентов страдает от нарушений сердечной деятельности и до 10% - от
изменений в органах пищеварения (характерна гипертрофия пищевода или толстой
кишки), нервной системе или целом ряде органов. В последующие годы инфекция может
приводить к внезапной смерти или сердечной недостаточности, вызываемой
прогрессивным разрушением сердечной мышцы.
В основе патогенеза болезни Шагаса лежат
токсико-аллергические реакции. Вследствие поражения токсином нервно-мышечного
аппарата пищеварительного тракта могут возникать патологическое расширение
просвета в том или ином его отделе (мегаэзофагус, мегадуоденум, мегасигма,
мегаколон) и ахалазия кардии (показано, что последняя при болезни Шагаса
сопровождается 33-кратным увеличением риска развития плоскоклеточного рака
пищевода). Развиваются воспалительно-дистрофические изменения (иногда
некробиотического характера) в миокарде, скелетных мышцах. В головном и спинном
мозге на вскрытии обнаруживаются кровоизлияния. В надпочечниках возникают
воспалительные изменения, в печени - жировая дегенерация гепатоцитов. Вокруг
поражённых трипаносомами клеток отмечаются инфильтраты из лейкоцитов.
Естественная восприимчивость людей высокая;
среди механизмов передачи - переливание заражённой крови, врождённая форма или
молоко инфицированной матери (см. Приложение №2). [7,9]
Саркоциста
Саркоциста, или саркоспоридия (Sarcocystis
lindemanni), морфологически близка к токсоплазме. Случаи нахождения
саркоспоридий у людей описаны в Америке, Азии, Африке. Вероятно, эти паразиты
распространены повсеместно, однако известны лишь немногие случаи
саркоспорилиоза человека.
Саркоспоридиозы человека зачастую протекают
бессимптомно и трудно диагностируются, человек при этом может выступать в роли
как основного, так и промежуточного хозяина саркоцист.
Кишечный саркоспоридиоз наблюдается в случае,
когда человек выступает в роли основного хозяина и вызывается видами S.
hominis, S. suihominis и S. bovihominis. Инфицирование происходит при
употреблении недостаточно обработанного (полусырого) мяса (свинины, говядины),
содержащего саркоцисты, протекание обычно бессимптомно, в некоторых случаях
сопровождается диспепсическими явлениями, лихорадкой, ознобом. Выделение
спороцист с калом начинается на 10-й - 13-й день после инфицирования и может
длиться до шести месяцев. Кишечный саркоспоридиоз достаточно широко
распространён.
Мышечный саркоспоридиоз возникает при
инфицировании спороцистами, когда человек выступает в роли промежуточного
хозяина и вызывается S. lindemanni, инфицирование происходит спорозоитами,
которые при проникновении в скелетные мышцы и миокард образуют цисты, которые
впоследствии могут обезыствляться. В некоторых случаях сопровождается миалгией
и общим недомоганием, встречается крайне редко.
Попадая в пищеварительный тракт человека с
пищей, цисты вскрываются в желудке и тонкой кишке, проникают в кровеносные
сосуды и с током крови разносятся по всему телу. Оседая затем в мышцах
конечностей, гортани, языка, сердца, они образуют новые цисты. Вместе с тем
даже при интенсивном поражении паразитами саркоспоридиоз у человека может
протекать бессимптомно. При гистологических исследованиях в мышцах находят
мелкие кровоизлияния. [5,6]
Шистосомы
У человека встречается 3 вида рода Schistosoma..
haematobium, паразитирует в кровеносных сосудах мочевого пузыря, возбудитель
мочеполового, или уринарного, шистосомоза. Яйца крупные, желтой окраски,
удлиненно-овальной формы, на одном из полюсов имеют большой шип.. mansoni,
паразитирует в венах толстого кишечника и брюшной полости, возбудитель кишечного
шистосомоза. Яйца крупные, желтоватого цвета, удлиненно-овальной формы,
снабжены крупным боковым шипом..japonicum, .локализуется в венах кишечника и
брюшной полости, возбудитель кишечного (японского) шистосомоза. Яйца овальной
формы, по длине вдвое меньше, чем у предыдущих видов, в ряде случаев виден
незначительно выраженный боковой шип.
Проникая через стенки кровеносных сосудов, яйца
шистосом скапливаются в просвете мочевого пузыря или кишечника и выделяются
наружу. При попадании в водоем происходит развитие личинок в моллюсках. Затем
личинки покидают промежуточного хозяина и активно проникают через кожу в тело
человека
В основе патогенеза шистосомоза лежат
токсико-аллергические реакции, обусловленные секретами желез при внедрении
паразитов и продуктами жизнедеятельности и распада гельминтов. В эпидермисе
вокруг мест внедрения церкариев развиваются отеки с лизисом клеток эпидермиса.
По ходу миграции личинок в коже возникают инфильтраты из лейкоцитов и
лимфоцитов.
Является наиболее частой причиной развития
пресинусоидальной портальной гипертензии. Личинки паразита попадают в венулы
воротной системы печени и закупоривают их. В результате снижается общая площадь
просвета венул портальной системы и развивается пресинусоидальная ПГ. При этом
давление в центральных венах печеночных долек остается нормальным.
Поражения сердца
1. Диффузный миокардит
Болезнь Шагаса
(возбудитель - Тгуpanasoma cruzi)
Первичная острая форма этого заболевания
наблюдается главным образом у детей, причем при клинически выраженных случаях
летальность достигает 10%. При вскрытии трупа обнаруживают увеличенное сердце с
дряблыми мышцами и расширенными камерами. В интерстициальной ткани при
микроскопическом исследовании выявляется отечность и диффузный инфильтрат,
состоящий из лимфоцитов и плазматических клеток. В мышечных волокнах
наблюдается гиалиновое перерождение и дегенеративные изменения, иногда в них
выявляются амастиготы.
Клинически острый миокардит проявляется
тахикардией, аритмиями и изменениями на электрокардиограммах. У некоторых
больных поражение сердца является непосредственной причиной смерти. Паразиты
обнаруживаются в крови, а длительный курс химиотерапии может привести к
ликвидации паразитемии и улучшить долгосрочный прогноз.
При хронической трипаносомозной кардиомиопатии сердца
гипертрофировано. В характерных случаях верхушка сердца расширена, а толщина
сердечной мышцы уменьшена. В результате чего образуется аневризма, которая
может распространяться на оба желудочка; кроме того, может быть расширен и
легочный конус. Нередко в области верхушки сердца и предсердий в сердечной
мышце образуются тромбы, которые могут стать причиной появления эмболов.
Предсердно-желудочковые отверстия расширены, хотя сами клапаны непосредственно
не повреждены. При микроскопическом исследовании выявляется гипертрофия части
мышечных волокон, а в остальных - очаговые некрозы и зернистая дегенерация.
Клеточные инфильтраты имеют очаговый характер и состоят из моноцитов,
лимфоцитов и плазматических клеток; могут быть выявлены участки очагового
фиброза. Проводящие волокна избирательно повреждены участками воспаления,
причем поражения чаще всего располагаются в области синусопредсердных и
предсердножелудочковых узлов, правой ножки и передней веточки левой ножки
предсердно-желудочкового пучка. При хронических поражениях сердца паразиты в
его тканях обнаруживаются очень редко.[1,4]
Легкие формы поражения сердца протекают
бессимптомно или обнаруживаются только на электрокардиограммах. Клинические
признаки поражения сердца появляются у больных старше 20 лет в виде
сердцебиения, головокружения, болей в области сердца и его увеличения,
недостаточности митрального и трехстворчатого клапанов, тромбоэмболии,
правосторонней сердечной недостаточности; одышка развивается редко. Ежегодно
умирает 0.7% больных c поражениями сердца. Внезапная смерть регистрируется в
38% случаев, а остальные больные погибают от прогрессирующей сердечной
недостаточности. При рентгенологическом исследовании органов грудной клетки
обнаруживается генерализованная кардиомегалия. На электрокардиограммах чаще
всего выявляются блокада правой ножки предсердно-желудочкового пучка,
желудочковая экстрасистолия, предсердно-желудочковая блокада I степени, а также
изменения зубца T и сегмента ST. При тяжелых формах заболевания может
наблюдаться полная атриовентрикулярная блокада, трепетание предсердий или
блокада левой ножки предсердно-желудочкового пучка. Серологические реакции с
антигенами Т. cruzi положительны у всех, а результаты ксенодиагностики - у 50%
больных. Химиотерапия не дает благоприятного эффекта, а поддерживающую терапию
проводить довольно трудно.
При экстрасистолиях хорошие результаты при
применении прокаинамида; дигоксин следует назначать с осторожностью, так как
его прием может сопровождаться нежелательными побочными явлениями со стороны
сердца, особенно в тех случаях, когда одновременное использование диуретиков
приводит к развитию гипокалиемии. Пропранолол и
другие бета-блокаторы могут приводить к развитию брадикардии, шоку и даже
смерти больного. [1,6]
Африканский трипаносомоз
(возбудитель - Trypanosoma brucei)
Острый миокардит при африканском трипаносомозе
наблюдается нередко и может даже привести к летальному исходу. При сонной
болезни на аутопсии обнаруживаются менее выраженные, обычно хронические
изменения, которые редко при жизни больных проявляются клиническими симптомами.
При заболеваниях, вызнанных T.b. rhodesiense, патологические изменения в сердце
сходны с таковыми при острых инвазиях, обусловленных Т. cruzi. Сердце
расширено, имеются признаки дегенерации сердечных волокон с клеточной
инфильтрацией и отеком интерстициальной ткани. Кроме того, в миокарде и
перикарде могут развиваться весьма обширные периваскулярные лимфоцитарные
инфильтраты. Нередко обнаруживается небольшой выпот в полости перикарда, иногда
сочетающийся с острым плевритом.
Клинически миокардит, вызванный T.b.
rhodesiense, проявляется увеличением сердца, сердечной недостаточностью и
нарушениями ритма сердечных сокращений (например, трепетанием предсердий). На
ЭКГ нередко видны экстрасистолы и предсердно-желудочковая сердечная блокада I
степени. В толстых мазках крови паразиты обнаруживаются постоянно.
Переносимость дигоксина достаточно хорошая, поэтому данный препарат в сочетании
с диуретиками применяют для поддерживающей терапии и начале лечения, пока не
проявляется благоприятный эффект специфической химиотерапии. Неблагоприятных
отдаленных последствий применения препаратов не отмечено.[2]
Токсоплазмоз
(возбудитель-Toxoplasma gondii)
При диссеминированных формах токсоплазмоза,
развивающихся у больных с иммунологическим дефицитом, клинические проявления
токсоплазменного миокардита могут быть весьма значительными. У таких больных
они сопровождаются развитием гепатоспленомегалии, энцефалита или пневмонии. При
обычном приобретенном токсоплазмозе нередко, вероятно, развивается очень легкая
форма миокардита, однако в подавляющем большинстве случаев она протекает
бессимптомно и лишь у отдельных больных имеет выраженные клинические признаки.
В любом случае токсоплазмы размножаются внутри
клеток сердечной мышцы, при разрыве которых возникают очаги интенсивного
воспаления, приводящие к поражению расположенных по соседству клеток сердечных
тканей.
Клинически поражения сердца при токсоплазмозе
проявляются симптомами острого миокардита; при наличии признаков поражения
сердца существенное значение имеет поддерживающая терапия; необходимо проводить
и специфическую химиотерапию.[1, 6,7]
Трихинеллез
(возбудитель - Trichinella spiralis)
При тяжелых формах инвазий, вызванный T.
spiralis поражения миокарда наблюдаются нередко и являются важной причиной
летальных исходов. Попадающие в миокард личинки трихинелл обуславливают
появление множественных воспалительных очагов в интерстициальной ткани; при
этом, как правило, имеются и другие клинические признаки трихинеллезной
инвазии. Настоящие цисты в сердечной мышце не формируются. Поражения сердца
трихинеллами проявляются его увеличением, аритмиями или сердечной
недостаточностью. Для подавления клеточных реакций наряду с химиотерапией
следует назначать кортикостероиды. По окончании острой стадии заболевания
трихинеллезом остаточных явлений после предшествующего поражения сердца, как
правило, не бывает.[1,7]
. Легочная гипертензия
Шистосомоз
(возбудитель - род Shistosoma)
Яйца Shistosoma haematobium попадают
непосредственно в легкие из венозных сосудистых сплетений через нижнюю полую
вену, правые предсердия и желудочек, а затем через легочную артерию. При
кишечном шистосомозе, вызванном S. mansoni и S. japonicum, яйца шистосом могут
попадать в легкие только после развития (в результате портальной гипертензии)
коллатералей, через которые яйца из воротной вены проникают в общий венозный
кровоток. S. haematobium обычно вызывают более легкие поражения легочных
сосудов, чем S. mansoni или S. japonicum, хотя патологические изменения в
легких характерны для поздних стадий инвазий, вызванных последними двумя
паразитами. [4]
Гранулемы вокруг яиц шистосом в легочных
артериях приводят к появлению некротических очагов с разрушением внутренней
оболочки сосудов и их закупоркой. Кровообращение в некоторых сосудах восстанавливается,
однако при этом формируются гемангиомы. Наличие множественных очагов приводит к
повышению давления в легочной артерии, в результате чего происходит гипертрофия
срединной оболочки, гиалиновый тромбоз и артерииты. Позже в легочной артерии образуются
аневризмы, появляются атеросклеротические изменения и гипертрофия правого
желудочка. Больные жалуются на одышку с затруднением выдоха и общую слабость,
позже развивается правосторонняя сердечная недостаточность. На более поздних
стадиях у части больных появляется легкий или умеренно выраженный цианоз из-за
формирования артериовенозных легочных анастомозов или бронхолегочных шунтов.
Кроме того, у больных с тяжелой легочной гипертензией образуются
воротно-легочные шунты и появляется симптом «барабанных палочек». Клинические
признаки - выраженная левосторонняя парастернальная эмфизема и расщепление
второго сердечного тона с акцентуацией легочного компонента; могут появляться
признаки гипертрофии и недостаточности правого желудочка. При рентгенологическом
исследовании виден расширенный легочный конус и усиленный прикорневой рисунок
за счет расширения легочных артерий и увеличения числа их ветвей. На
электрокардиограммах видна гипертрофия правого желудочка и повышение
внутрижелудочкового давления; нарушения сердечного ритма выявляются редко. Эти
изменения иногда бывает трудно дифференцировать с «легочным сердцем» другой
этиологии даже с врожденными заболеваниями сердца. Химиотерапия останавливает
развитие патологических изменений, однако необходима также поддерживающая
терапия.
При начале химиотерапии у больных с
несложненными инвазиями, вызванными S. haematobium, может происходить эмболия
легочных сосудов взрослыми гельминтами; соответствующие симптомы вскоре
исчезают, хотя у некоторых больных может сохраняться одышка и кашель. При
рентгенологическом исследовании выявляются транзиторные затемнения в легких,
отражающие наличие тканевой реакции вокруг погибших гельминтов.[1,8]
. Перикардит и поражения перикарда
Амебиаз
(возбудитель - Entamoeba histolytica)
Амебный абсцесс в левой доле печени может
увеличиваться и распространяться на перикард; реже источником повреждения
перикарда является абсцесс в правой доле печение или в легком. В полости
перикарда скапливается серозный выпот, однако в дальнейшем развивается гнойный
амебный перикардит. У больных может развиться шок вследствие тампонады сердца;
иногда заболевание развивается постепенно и сопровождается появлением
характерных симптомов перикардита. Нередкие признаки - боль за грудиной и шум
трения перикарда. Определение этиологии перикардита затруднено, если наличие
амебного абсцесса печение до этого не было установлено. В таких случаях чаще
всего устанавливают предположительный диагноз туберкулезного перикардита.
Существенное терапевтическое значение имеет аспирация жидкости из полости
перикарда. Эту манипуляцию производят в качестве экстренного мероприятия, но
нередко ее приходится в дальнейшем осуществлять повторно. Следует также
производить аспирацию амебного абсцесса печени. Химиотерапию проводят так же,
как и при амебном абсцессе печени. Спаечный перикардит - редкое позднее
осложнение, требующее иногда выполнения перикардэктомии.[7,8]
. Очаговые повреждения миокарда
Эхинококковая киста
Примерно 1% эхинококковых кист локализуется в
миокарде, обычно одиночные образования. Некоторые кисты погибают, на их месте
остается густая масса казеозного вещества. Оставшиеся кисты продолжают расти и
через 1-5 лет прорываются в полость сердца или реже - в полость перикарда. При
таком разрыве может развиться анафилактический шок со смертельным исходом.
Разрыв эхинококковой кисты в полость перикарда в дальнейшем может привести к
формированию дочерних кист, которые со временем вызовут нарушения функции
сердца. Прорыв кисты в полость сердца чаще происходит справа, в результате чего
возникает множество вторичных легочных кист. Истечение содержимого кисты в
левые предсердие или желудочек приводят к обширной диссеминации паразитоза по
артериальной системе; частым следствием этого являются множественные кисты в
головном мозге.
Так как прогноз при эхинококковых кистах в
миокарде плохой, следует производить их хирургическое удаление. Однако у
большей части больных эхинококковые кисты сердца существуют бессимптомно и
выявляются только после их разрыва.[1,3,7]
Цистицеркоз
(возбудитель - Taenia solium)
Цистицерки в организме человека нередко
локализуются в миокарде, однако такие поражения протекают обычно бессимптомно.
У всех больных при этом существуют обязательно цисты в других тканях и органах.
Наличие большого числа цист может привести к сердечной недостаточности из-за
возникновения механических повреждений, однако чаще наблюдаются поражения
проводящей системы или нарушения сердечного ритма вследствие специфической
локализации цист. Так как прогноз при этой атипичной локализации паразитов
плохой, следует производить их хирургическое удаление.[7,8]
Гетерофиаз
(возбудитель - Heterophyes)
Описано несколько случаев выявления очаговых
гранулем в тканях сердца вокруг эктопических яиц мелких кишечных трематод
Heterophyes и некоторых других близких к этим гельминтам видов паразитов.
Особенно часто такие заболевания выявляли на Филиппинах. У большинства больных
очаги поражения локализовались в миокарде, хотя описаны еще случаи поражения
сердечных клапанов. У некоторых больных такие поражения приводили к развитию
сердечной недостаточности и даже смерть.[6,8]
Заключение
Паразиты приспособились к обитанию во всех
органах и тканях человека и животных. Паразит каждого вида имеет специфическую
локализацию (например, малярийный плазмодий в эритроцитах). Иногда наблюдают
извращенную локализацию паразитов (фасциолы в сердце и матке). В таких случаях
паразиты скоро погибают вследствие неблагоприятных условий для их
существования.
Безусловно, паразиты наносят огромнейшие
токсические, механические воздействия на сердце и кровеносную систему.
Механическое действие оказывают взрослые особи и
личинки паразитов. Взрослые особи повреждают ткань сердца и стенок сосудов
присосками или частями ротового аппарата, нарушают прохождение крови по
сосудам, вызывают разрывы сосудов, сердечной ткани и т. д. Личинки повреждают
ткани во время миграции.
Токсическое действие вызывают продукты обмена
веществ, которые паразит выделяет в организме хозяина. Симптомами токсического
действия паразита на человека могут быть боли в груди, головная боль, тошнота и
другие явления.
Поселяясь в сердце, паразиты питаются кровью и
тканевой жидкостью, и в этих благоприятных условиях они размножаются.
У одного человека одновременно может обитать от
небольшого количества до десятков видов паразитов нередко при высокой степени
заражения.
Обусловленные паразитами тяжелые поражения у
человека развиваются преимущественно по двум причинам. Во-первых, паразиты,
недавно попавшие к человеку от животных, имеют тенденцию к патогенности из-за
их слабой адаптации к организму человека; в качестве примеров можно назвать
африканский и американский трипаносомозы; это относится, по-видимому, и к
злокачественной тропической малярии, хотя происхождение ее возбудителей
остается спорным. Во-вторых, тяжелые поражения могут быть следствием повторной
реинвазии паразитическими простейшими или высокой интенсивности метазойной
инвазии.[8]
Список литературы
Найт,
Р. Паразитарные болезни: учебник / Пер. с англ. - М.: Медицина, 1985, 219-227
с.
«Всемирная
организация здравоохранения 2015 г.» Центр СМИ
Информационная
бюллетень №259 (электронный ресурс) - режим доступа:
#"873374.files/image001.gif">
Plasmodium ovale в мазке крови


Plasmodium vivax в мазке крови
№2. Жизненный цикл Trypanosoma gambiense и
Trypanosoma rhodesiense. - инфекционная стадия; d - диагностическая стадия.

Trypanasoma cruzi в мазке крови

№3. Жизненный цикл шистосом на примере
Shistosoma mansoni: А - окончательный хозяин паразита - человек; 1а - самец и
самка шистосом, копулирующие в брыжеечных венах; 1б - инвазионное яйцо
Shistosoma mansoni, отложенное самкой в вене; 2 - мирацидий в воде водоемов; Б
- моллюск из рода Peanorbis; 3 - церкарии, вышедшие из моллюска в воду водоема,
внедряются через кожу или слизистые оболочки в организм человека.

